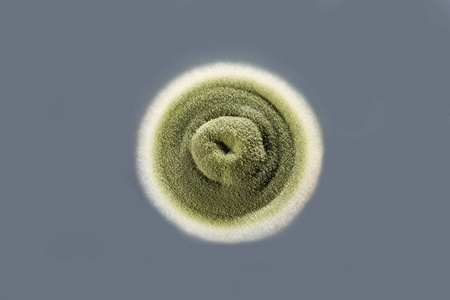
真菌菌落图片

光滑型菌落图片

菌落形态图片.jpg
图片尺寸887x1920
【专题】各种念珠菌菌落形态图片欣赏
图片尺寸1024x768
想问下平板中那几个呈黄色的菌落是什么菌 - 食品微生物检测 - 食品
图片尺寸800x1068
这个是什么菌落
图片尺寸700x934
我的微观世界 菌落光滑至麂皮状,干燥,扁平,烟褐色到棕黑色 - 抖音
图片尺寸1918x1880
帮忙看一下这是什么菌落
图片尺寸1024x768
血平板上菌落:大,白,湿润,光滑
图片尺寸1600x1200
真菌菌落图片
图片尺寸450x300
菌落光滑还是菌光滑?
图片尺寸700x524
有图,帮助鉴定菌落
图片尺寸3456x2592
请问前辈们这是什么菌落呢?
图片尺寸2938x3917
用的是在lb培养基上面长的菌落,菌落形似鼻涕样,突起,表面光滑,有一点
图片尺寸3264x2448
微生物菌落形态特征辨别
图片尺寸1840x3264
冷冻食品的菌落
图片尺寸2048x1360
微生物菌落.jpg
图片尺寸1444x1221
菌落形态确认
图片尺寸3120x4160
帮忙签定细菌总数检测出来的菌落是什么菌?
图片尺寸1800x3200
分泌物培养2 d可见灰色,光滑的细小菌落
图片尺寸430x394
关于孟加拉红培养基上的菌落,这都是霉菌吗
图片尺寸3120x4160
图2 真菌菌落3哪些因素会影响真菌检查结果?
图片尺寸643x482